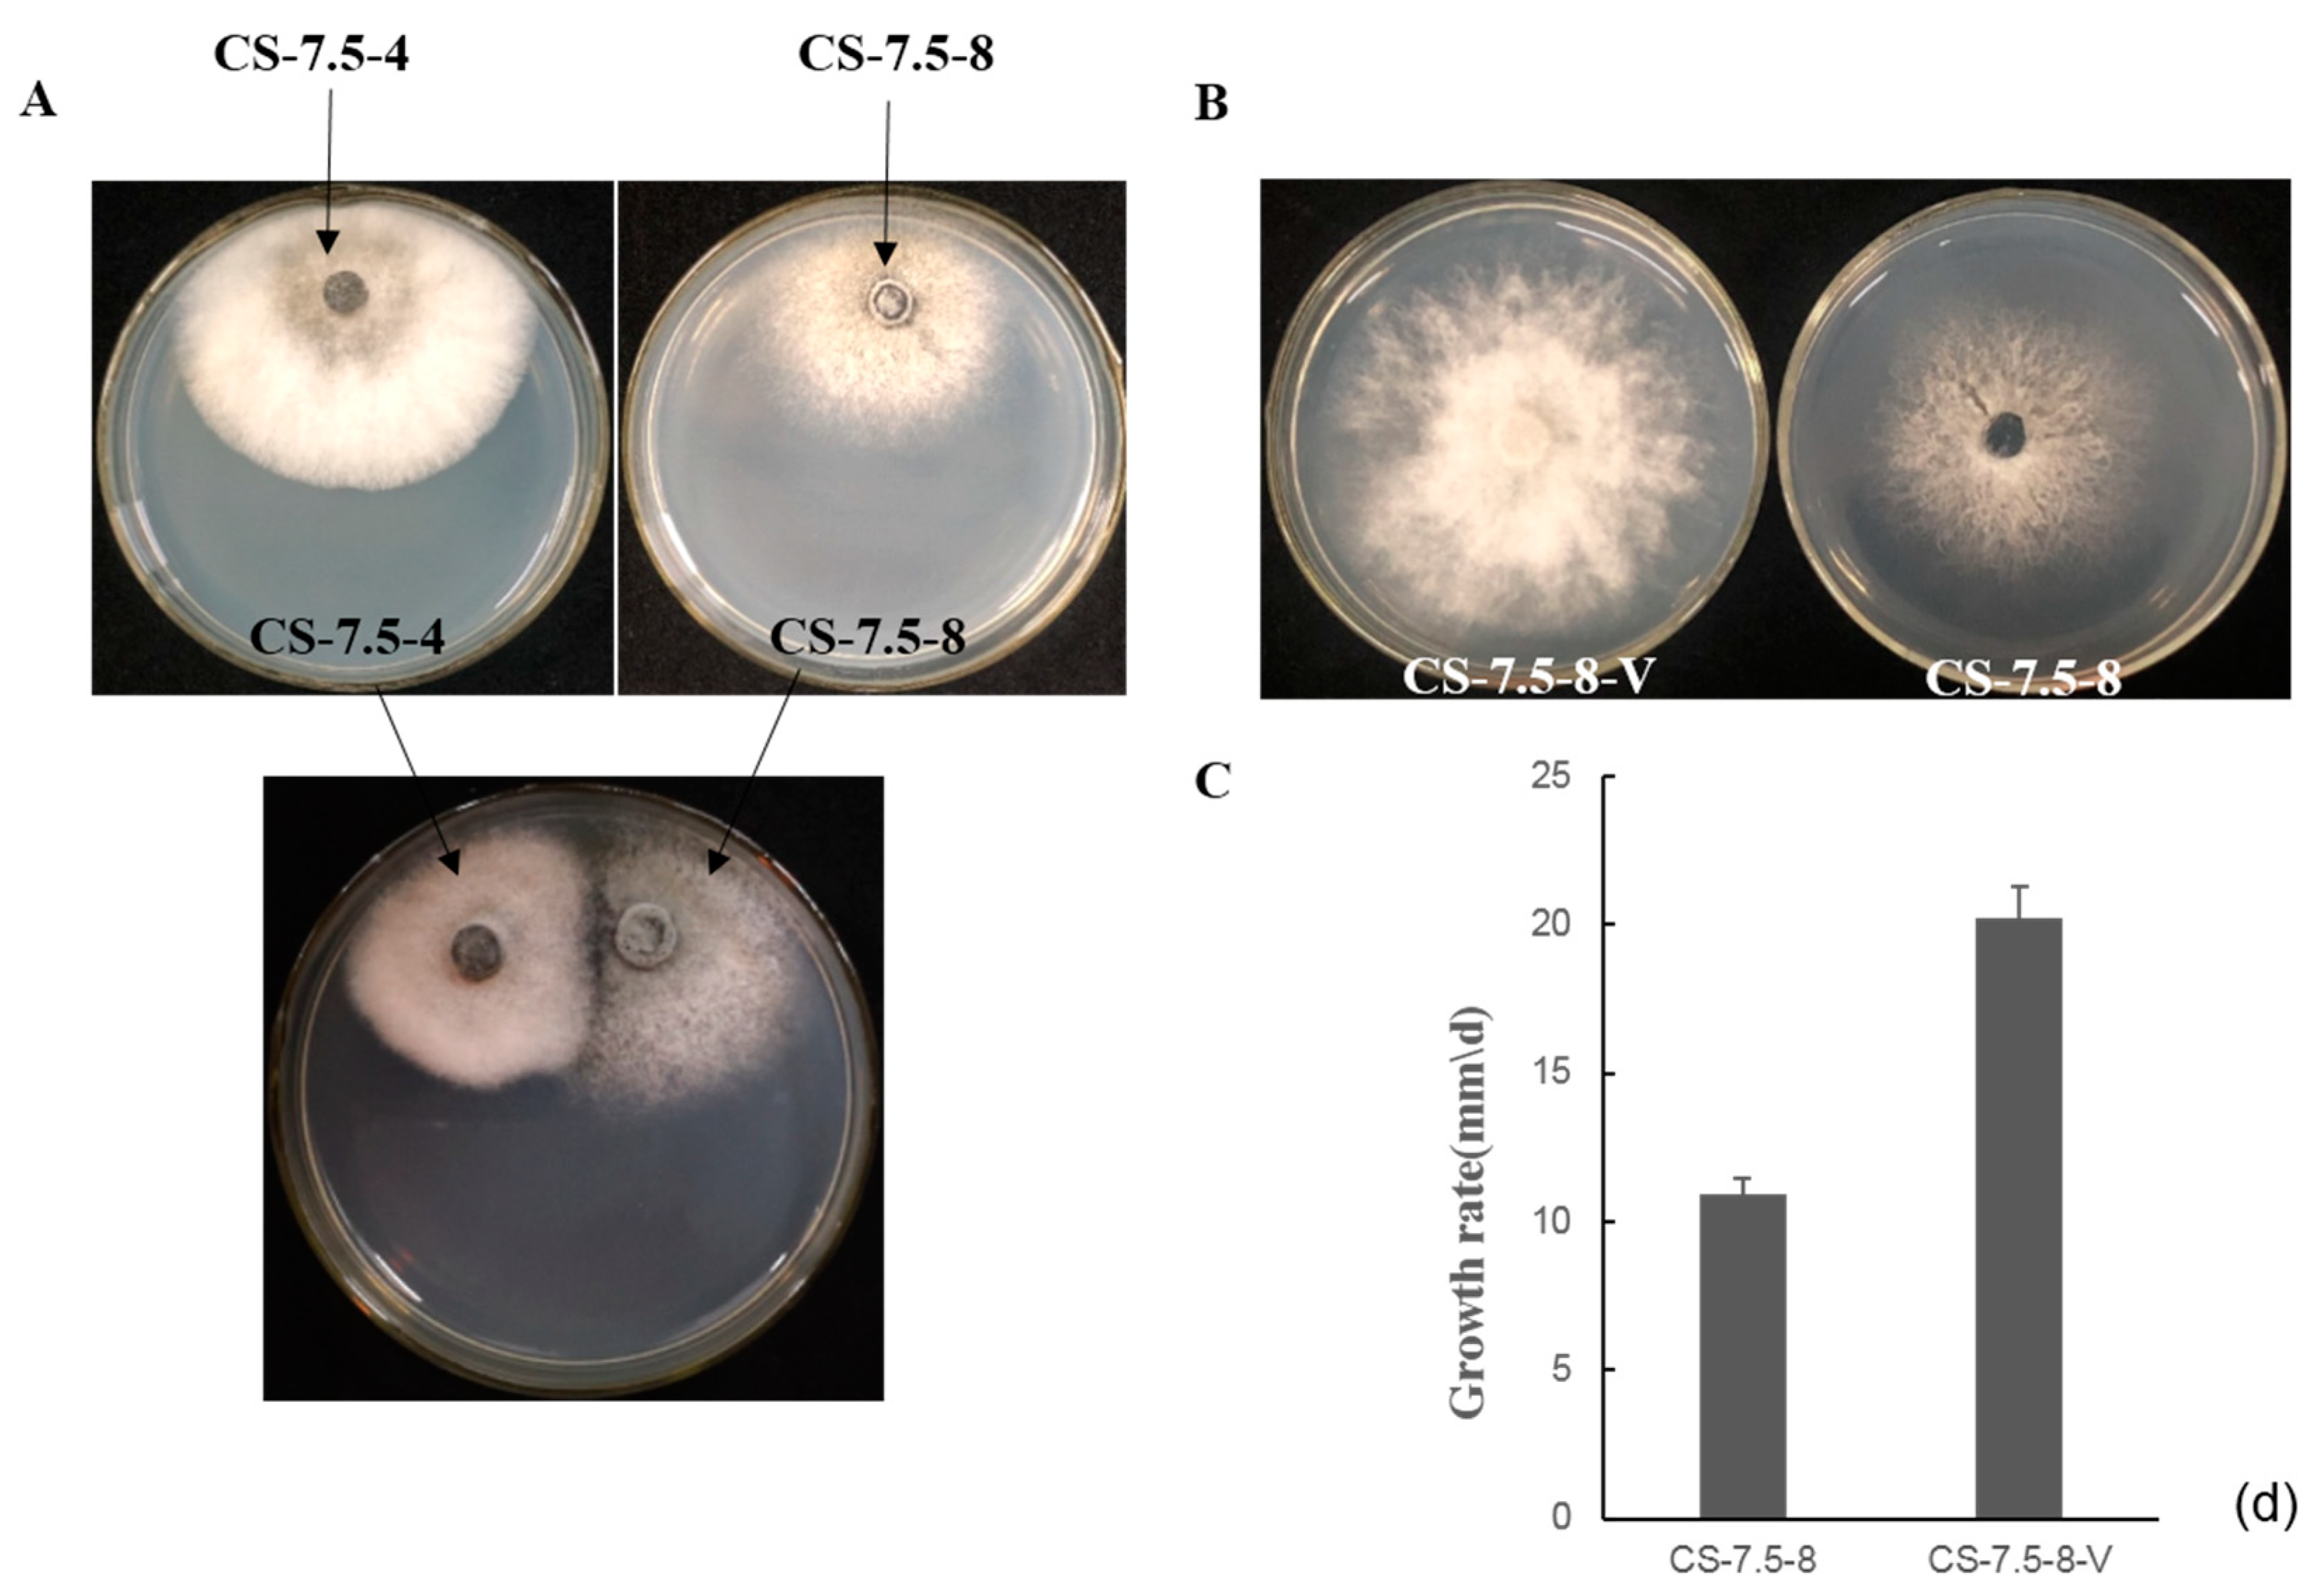
Viruses 11 00083 g007

A Victorivirus and Two Novel Mitoviruses Co-Infected the Plant Pathogen Nigrospora oryzae
Abstract
1. Introduction
2. Materials and Methods
2.1. Fungal Isolation and Identification
2.2. dsRNA Extraction and Purification
2.3. cDNA Synthesis, Molecular Cloning, and Sequencing
2.4. Sequence Analyses
2.5. Extraction of Viral Particles and SDS-PAGE
2.6. Horizontal Transmission of the Associated dsRNAs in N. oryzae
2.7. Extraction of the Total RNA and RT-PCR Detection of the Associated dsRNAs
3. Results
3.1. dsRNA Segments Isolated from Strain CS-7.5-4 of N. oryzae
3.2. Genome Sequence Analysis of the dsRNA-L in Strain CS-7.5-4
3.3. Genome Sequence Analysis of the dsRNA-M, S in Strain CS-7.5-4
3.4. Predicted Secondary Structures of the 5′-UTRs and 3′-UTRs for the NoMV1 and NoMV2
3.5. Phylogenetic Analysis of These Viruses Based on RdRps
3.6. Purification of Viral Particles from Strain CS-7.5-4
3.7. Horizontal Transmission of the Associated dsRNAs
4. Discussion
Supplementary Materials
Author Contributions
Funding
Conflicts of Interest
References
- Ghabrial, S.A.; Suzuki, N. Viruses of plant pathogenic fungi. Annu. Rev. Phytopathol. 2009, 47, 353–384. [Google Scholar] [CrossRef] [PubMed]
- Xie, J.; Jiang, D. New insights into mycoviruses and exploration for the biological control of crop fungal diseases. Annu. Rev. Phytopathol. 2014, 52, 45–68. [Google Scholar] [CrossRef] [PubMed]
- Nuss, D.L. Biological control of chestnut blight: An example of virus-mediated attenuation of fungal pathogenesis. Microbiol. Rev. 1992, 56, 561–576. [Google Scholar] [PubMed]
- Yu, X.; Li, B.; Fu, Y.; Jiang, D.; Ghabrial, S.A.; Li, G.; Peng, Y.; Xie, J.; Cheng, J.; Huang, J.; et al. A geminivirus-related dna mycovirus that confers hypovirulence to a plant pathogenic fungus. Proc. Natl. Acad. Sci. USA 2010, 107, 8387–8392. [Google Scholar] [CrossRef] [PubMed]
- Liu, L.; Xie, J.; Cheng, J.; Fu, Y.; Li, G.; Yi, X.; Jiang, D. Fungal negative-stranded RNA virus that is related to bornaviruses and nyaviruses. Proc. Natl. Acad. Sci. USA 2014, 111, 12205–12210. [Google Scholar] [CrossRef] [PubMed]
- Wu, M.; Deng, Y.; Zhou, Z.; He, G.; Chen, W.; Li, G. Characterization of three mycoviruses co-infecting the plant pathogenic fungus sclerotinia nivalis. Virus Res. 2016, 223, 28–38. [Google Scholar] [CrossRef] [PubMed]
- Yu, L.; Sang, W.; Wu, M.D.; Zhang, J.; Yang, L.; Zhou, Y.J.; Chen, W.D.; Li, G.Q. Novel hypovirulence-associated RNA mycovirus in the plant-pathogenic fungus Botrytis cinerea: Molecular and biological characterization. Appl. Environ. Microbiol. 2015, 81, 2299–2310. [Google Scholar] [CrossRef]
- Liu, H.; Fu, Y.; Xie, J.; Cheng, J.; Ghabrial, S.A.; Li, G.; Peng, Y.; Yi, X.; Jiang, D. Evolutionary genomics of mycovirus-related dsrna viruses reveals cross-family horizontal gene transfer and evolution of diverse viral lineages. BMC Evol. Biol. 2012, 12, 91. [Google Scholar] [CrossRef]
- Ghabrial, S.A.; Castón, J.R.; Jiang, D.; Nibert, M.L.; Suzuki, N. 50-Plus years of fungal viruses. Virology 2015, 479, 356–368. [Google Scholar] [CrossRef]
- Ghabrial, S.A.; Nibert, M.L. Victorivirus, a new genus of fungal viruses in the family Totiviridae. Arch. Virol. 2009, 154, 373–379. [Google Scholar] [CrossRef]
- Ghabrial, S.A.; Dunn, S.E.; Li, H.; Xie, J.; Baker, T.S. Virusesof Helminthosporium (Cochlioblus) victoriae. Adv. Virus Res. 2013, 86, 289–325. [Google Scholar]
- Wickner, R.B.; Ghabrial, S.A.; Nibert, M.L.; Patterson, J.L.; Wang, C.C. Family Totiviridae. In Virus Taxonomy: Classification and Nomenclature of Viruses, Ninth Report of the International Committee on Taxonomy of Viruses; King, A.M.Q., Adams, M.J., Carstens, E.B., Lefkowitz, E.J., Eds.; Elsevier Academic Press: London, UK, 2011; pp. 639–650. [Google Scholar]
- Li, H.; Havens, W.M.; Nibert, M.L.; Ghabrial, S.A. RNA sequence determinants of a coupled termination–reinitiation strategy for downstream ORF translation in HvV190S and other victoriviruses (family Totiviridae). J. Virol. 2011, JVI-00364. [Google Scholar] [CrossRef]
- Li, H.; Havens, W.M.; Nibert, M.L.; Ghabrial, S.A. An RNA cassette from Helminthosporium victoriae virus 190S necessary and sufficient for stop/restart translation. Virology 2015, 474, 131–143. [Google Scholar] [CrossRef] [PubMed]
- Wu, M.; Zhang, J.; Yang, L.; Li, G. RNA Mycoviruses and Their Role in Botrytis, Biology. In Botrytis—The Fungus, the Pathogen and its Management in Agricultural Systems; Springer: Cham, Switzerland, 2016. [Google Scholar]
- Hillman, B.I.; Esteban, R. Family Narnaviridae. In Virus Taxonomy: Classification and Nomenclature of Viruses, Ninth Report of the International Committee on Taxonomy of Viruses; King, A.M.Q., Adams, M.J., Carstens, E.B., Lefkowitz, E.J., Eds.; Elsevier AcademicPress: London, UK, 2011; pp. 1055–1060. [Google Scholar]
- Zoll, J.; Verweij, P.E.; Melchers, W.J. Discovery and characterization of novel Aspergillus fumigatus mycoviruses. PLoS ONE 2018, 13, e0200511. [Google Scholar] [CrossRef] [PubMed]
- Kottaloizou, I.; Coutts, R.H. Studies on the Virome of the Entomopathogenic Fungus Beauveria bassiana Reveal Novel dsRNA Elements and Mild Hypervirulence. PLoS Pathog. 2017, 13, e1006183. [Google Scholar]
- Li, L.; Pan, H.; Chen, M.Y.; Zhang, S.; Zhong, C. First report of nigrospora oryzae causing brown/black spot disease of Kiwifruit in China. Plant Dis. 2017, 102, 243. [Google Scholar] [CrossRef]
- Zhang, L.X.; Li, S.S.; Tan, G.J.; Shen, J.T.; He, T. First report of nigrospora oryzae causing leaf spot of cotton in China. Plant Dis. 2012, 96, 1379. [Google Scholar] [CrossRef]
- Zhai, L.F.; Liu, J.; Zhang, M.X.; Hong, N.; Wang, G.P.; Wang, L.P. The first report of leaf spots in aloe vera caused by nigrospora oryzae in China. Plant Dis. 2013, 97, 1256–1257. [Google Scholar] [CrossRef]
- Eken, C.; Spanbayev, A.; Tulegenova, Z.; Yechshzhanov, T. First report of nigrospora oryzae on wheat in Kazakhstan. Plant Dis. 2016, 100, 861. [Google Scholar] [CrossRef]
- Yu, J.X.; Zhu, J.Z.; Wang, Y.; Zhang, C.J.; Zhong, J.; Zhu, H.J.; Da Gao, B.; Zhou, Q. Molecular characterization of a putative gammapartitivirus in the phytopathogenic fungus Nigrospora oryzae. Arch. Virol. 2018, 163, 1091–1095. [Google Scholar] [CrossRef]
- Zhong, J.; Zhao, S.Q.; Li, G.F.; Pang, X.D.; Deng, X.J.; Zhu, H.J.; Da Gao, B.; Zhou, Q. A novel fusarivirus isolated from the phytopathogenic fungus nigrospora oryzae. Virus Genes 2016, 52, 891–895. [Google Scholar] [CrossRef] [PubMed]
- Morris, T.J.; Dodds, J.A. Isolation and analysis of double-stranded rna from virus-infected plant and fungal tissue. Phytopathology 1979, 69, 854–858. [Google Scholar] [CrossRef]
- Xie, J.; Xiao, X.; Fu, Y.; Liu, H.; Cheng, J.; Ghabrial, S.A.; Li, G.; Jiang, D. A novel mycovirus closely related to hypoviruses that infects the plant pathogenic fungus sclerotinia sclerotiorum. Virology 2011, 418, 49–56. [Google Scholar] [CrossRef] [PubMed]
- Zhong, J.; Lei, X.H.; Zhu, J.Z.; Song, G.; Zhang, Y.D.; Chen, Y.; Da Gao, B. Detection and sequence analysis of two novel co-infecting double-strand rna mycoviruses in Ustilaginoidea virens. Arch. Virol. 2014, 159, 3063–3070. [Google Scholar] [CrossRef] [PubMed]
- Larkin, M.A.; Blackshields, G.; Brown, N.P.; Chenna, R.; McGettigan, P.A.; McWilliam, H.; Valentin, F.; Wallace, I.M.; Wilm, A.; Lopez, R.; et al. Clustal W and Clustal X version 2.0. Bioinformatics 2007, 23, 2947–2948. [Google Scholar] [CrossRef] [PubMed]
- Tamura, K.; Stecher, G.; Peterson, D.; Filipski, A.; Kumar, S. MEGA6: Molecular Evolutionary Genetics Analysis Version 6.0. Mol. Biol. Evol. 2013, 30, 2725–2729. [Google Scholar] [CrossRef] [PubMed]
- Chiba, S.; Salaipeth, L.; Lin, Y.H.; Sasaki, A.; Kanematsu, S.; Suzuki, N. A novel bipartite double-stranded rna mycovirus from the white root rot fungus rosellinia necatrix: Molecular and biological characterization, taxonomic considerations, and potential for biological control. J. Virol. 2009, 83, 12801–12812. [Google Scholar] [CrossRef]
- Sasaki, A.; Kanematsu, S.; Onoue, M.; Oyama, Y.; Yoshida, K. Infection of Rosellinia necatrix with purified viral particles of a member of Partitiviridae (RnPV1-W8). Arch. Virol. 2006, 151, 697–707. [Google Scholar] [CrossRef]
- Hao, F.; Ding, T.; Wu, M.; Zhang, J.; Yang, L.; Chen, W.; Li, G. Two Novel Hypovirulence-Associated Mycoviruses in the Phytopathogenic Fungus Botrytis cinerea: Molecular Characterization and Suppression of Infection Cushion Formation. Viruse 2018, 10, 254. [Google Scholar] [CrossRef]
- Hong, Y.; Dover, S.L.; Cole, T.E.; Brasier, C.M.; Buck, K.W. Multiple Mitochondrial Viruses in an Isolate of the Dutch Elm Disease Fungus Ophiostoma novo-ulmi. Virology 1999, 258, 118–127. [Google Scholar] [CrossRef]
- Mathews, D.H. Using an rna secondary structure partition function to determine confidence in base pairs predicted by free energy minimization. RNA 2004, 10, 1178–1190. [Google Scholar] [CrossRef] [PubMed]
- Zhou, Q.; Zhong, J.; Hu, Y.; da Gao, B. A novel nonsegmented double-stranded RNA mycovirus identified in the phytopathogenic fungus Nigrospora oryzae shows similarity to partitivirus-like viruses. Arch. Virol. 2016, 161, 229–232. [Google Scholar] [CrossRef] [PubMed]
- Zhong, J.; Zhou, Q.; Hu, Y.; Zhu, H.J.; Da Gao, B. Molecular identification of a novel victorivirus from the phytopathogenic fungus Nigrospora oryzae. Virus Genes 2016, 52, 156–159. [Google Scholar] [CrossRef] [PubMed]
- Cole, T.E.; Hong, Y.; Brasier, C.M.; Buck, K.W. Detection of an RNA-dependent RNA polymerase in mitochondria from a mitovirus-infected isolate of the Dutch Elm disease fungus, Ophiostoma novo-ulmi. Virology 2000, 268, 239–243. [Google Scholar] [CrossRef] [PubMed]
- Xie, J.; Ghabrial, S.A. Molecular characterizations of two mitoviruses co-infecting a hyovirulent isolate of the plant pathogenic fungus Sclerotinia sclerotiorum. Virology 2012, 428, 77–85. [Google Scholar] [CrossRef] [PubMed]
- Khalifa, M.E.; Pearson, M.N. Molecular characterisation of novel mitoviruses associated with Sclerotinia sclerotiorum. Arch. Virol. 2014, 159, 3157–3160. [Google Scholar] [CrossRef] [PubMed]
- Doherty, M.; Coutts, R.H.; Brasier, C.M.; Buck, K.W. Sequence of RNA-dependent RNA polymerase genes provides evidence for three more distinct mitoviruses in Ophiostoma novo-ulmi isolate Ld. Virus Genes 2006, 33, 41–44. [Google Scholar] [CrossRef]
- Sasaki, A.; Nakamura, H.; Suzuki, N.; Kanematsu, S. Characterization of a new megabirnavirus that confers hypovirulence with the aid of a co-infecting partitivirus to the host fungus, Rosellinia necatrix. Virus Res. 2016, 219, 73–82. [Google Scholar] [CrossRef]
- Wu, M.D.; Zhang, L.; Li, G.Q.; Jiang, D.H.; Hou, M.S.; Huang, H.C. Hypovirulence and double-stranded RNA in Botrytis cinerea. Phytopathology 2007, 97, 1590–1599. [Google Scholar] [CrossRef]
- Deng, F.; Xu, R.; Boland, G.J. Hypovirulence-associated double-stranded RNA from Sclerotinia homoeocarpa is conspecific with Ophiostoma novo-ulmi mitovirus 3a-Ld. Phytopathology 2003, 93, 1407–1414. [Google Scholar] [CrossRef]
- Khalifa, M.E.; Pearson, M.N. Molecular characterization of three mitoviruses co-infecting a hypovirulent isolate of Sclerotinia sclerotiorum fungus. Virology 2013, 441, 22–30. [Google Scholar] [CrossRef] [PubMed]
- Xu, Z.; Wu, S.; Liu, L.; Cheng, J.; Fu, Y.; Jiang, D.; Xie, J. A mitovirus related to plant mitochondrial gene confers hypovirulence on the phytopathogenic fungus Sclerotinia sclerotiorum. Virus Res. 2015, 197, 127–136. [Google Scholar] [CrossRef] [PubMed]
- Hu, Z.; Wu, S.; Cheng, J.; Fu, Y.; Jiang, D.; Xie, J. Molecular characterization of two positive-strand RNA viruses co-infecting a hypovirulent strain of Sclerotinia sclerotiorum. Virology 2014, 464–465, 450–459. [Google Scholar] [CrossRef] [PubMed]
- Polashock, J.J.; Bedker, P.J.; Hillman, B.I. Movement of a small mitochondrial double-stranded RNA element of Cryphonectria parasitica: Ascospore inheritance and implications for mitochondrial recombination. Mol. Gen. Genet. MGG 1997, 256, 566–571. [Google Scholar] [CrossRef] [PubMed]

| Virus | CP | RdRp | ||||
|---|---|---|---|---|---|---|
| Identity (%) | E Value | Query Cover (%) | Identity (%) | E Value | Query Cover (%) | |
| HvV190S | 70.6 | 0.0 | 93.9 | 56.7 | 0.0 | 99.6 |
| BmV1 | 71.3 | 0.0 | 93.9 | 55.9 | 0.0 | 99.5 |
| BfTV1 | 58.7 | 0.0 | 98.4 | 48.2 | 0.0 | 99.9 |
| TcV1 | 61.9 | 0.0 | 92.1 | 47.6 | 0.0 | 99.6 |
| SnV1 | 57.7 | 0.0 | 91.9 | 44.9 | 0.0 | 99.4 |
| BbV1 | 56.7 | 0.0 | 92.9 | 42.1 | 0.0 | 99.5 |
| RnV1 | 59.3 | 0.0 | 84.8 | 41.7 | 0.0 | 99.6 |
| AfSV1 | 53.8 | 0.0 | 96.8 | 39.7 | 0.0 | 99.9 |
| UvRV1 | 51.7 | 0.0 | 96.3 | 40.1 | 0.0 | 99.8 |
| UvRVL | 51.4 | 0.0 | 99.7 | 40.9 | 0.0 | 99.0 |
| SsRV1 | 48.6 | 0.0 | 92.1 | 41.5 | 0.0 | 98.4 |
| SsV1 | 58.7 | 0.0 | 62.7 | 39.8 | 2 × 10−51 | 30.8 |
| UvRV5 | 44.3 | 5 × 10−166 | 84.8 | 39.1 | 5 × 10−150 | 93.5 |
| HmTV1-17 | 43.6 | 2 × 10−15 | 83.9 | 34.9 | 4 × 10−149 | 97.7 |
| NoRV1 | 39.1 | 5 × 10−126 | 91.9 | 35.1 | 2 × 10−115 | 91.6 |
| MoV1 | 39.4 | 1 × 10−124 | 78.6 | 37.7 | 1 × 10−176 | 99.4 |
| MoV3 | 39.2 | 2 × 10−123 | 91.5 | 34.9 | 5 × 10−112 | 94.9 |
| GaRVL1 | 39.2 | 9 × 10−118 | 84.7 | 36.9 | 1 × 10−115 | 84.7 |
| AaV1 | 39.4 | 2 × 10−116 | 90.9 | 37.0 | 5 × 10−110 | 82.9 |
| FpV1 | 35.6 | 7 × 10−116 | 93.5 | 36.0 | 2 × 10−105 | 75.5 |
| Virus | NoMV1(RdRp) | Virus | NoMV2(RdRp) | ||||
|---|---|---|---|---|---|---|---|
| Identity (%) | E Value | Query Cover (%) | Identity (%) | E Value | Query Cover (%) | ||
| SlaMV5 | 39.1 | 2 × 10−162 | 98.1 | AaMV1 | 42.3 | 0.0 | 99.3 |
| BcMV3 | 41.1 | 7 × 10−146 | 92.4 | SlaMV2 | 41.9 | 6 × 10−179 | 99.7 |
| FpMV3 | 37.0 | 3 × 10−145 | 92.4 | AbMV | 42.1 | 5 × 10−178 | 99.4 |
| SsMV28 | 35.3 | 8 × 10−129 | 93.2 | SlaMV4 | 52.2 | 2 × 10−156 | 62.5 |
| RsMV19 | 56.5 | 8 × 10−73 | 28.5 | FcMV2-1 | 38.4 | 1 × 10−153 | 99.3 |
| SsMV29 | 30.6 | 2 × 10−71 | 79.9 | GaMRV | 36.1 | 9 × 10−131 | 99.3 |
| RsMV20 | 54.1 | 8 × 10−71 | 27.5 | GMVS1 | 35.5 | 1×10−128 | 99.3 |
| RsMV4 | 32.7 | 1 × 10−54 | 49.6 | SsMV4 | 38.3 | 2 × 10−128 | 90.1 |
| RsMV13 | 26.9 | 5 × 10−54 | 76.7 | BcMV4 | 40.8 | 2 × 10−127 | 83.9 |
| MpMV3 | 31.0 | 4 × 10−51 | 58.7 | SnMV1 | 40.5 | 3 × 10−126 | 83.9 |
| SsMV6 | 31.9 | 5 × 10−51 | 58.6 | FpMV1 | 37.3 | 1 × 10−125 | 91.1 |
| ShMV | 32.6 | 3 × 10−49 | 58.1 | Omv4 | 36.7 | 2 × 10−116 | 89.9 |
© 2019 by the authors. Licensee MDPI, Basel, Switzerland. This article is an open access article distributed under the terms and conditions of the Creative Commons Attribution (CC BY) license (http://creativecommons.org/licenses/by/4.0/).
Share and Cite
Liu, H.; Liu, R.; Li, C.X.; Wang, H.; Zhu, H.J.; Gao, B.D.; Zhou, Q.; Zhong, J. A Victorivirus and Two Novel Mitoviruses Co-Infected the Plant Pathogen Nigrospora oryzae. Viruses 2019, 11, 83. https://doi.org/10.3390/v11010083
Liu H, Liu R, Li CX, Wang H, Zhu HJ, Gao BD, Zhou Q, Zhong J. A Victorivirus and Two Novel Mitoviruses Co-Infected the Plant Pathogen Nigrospora oryzae. Viruses. 2019; 11(1):83. https://doi.org/10.3390/v11010083
Chicago/Turabian StyleLiu, Hong, Rui Liu, Chang Xin Li, Hui Wang, Hong Jian Zhu, Bi Da Gao, Qian Zhou, and Jie Zhong. 2019. "A Victorivirus and Two Novel Mitoviruses Co-Infected the Plant Pathogen Nigrospora oryzae" Viruses 11, no. 1: 83. https://doi.org/10.3390/v11010083
APA StyleLiu, H., Liu, R., Li, C. X., Wang, H., Zhu, H. J., Gao, B. D., Zhou, Q., & Zhong, J. (2019). A Victorivirus and Two Novel Mitoviruses Co-Infected the Plant Pathogen Nigrospora oryzae. Viruses, 11(1), 83. https://doi.org/10.3390/v11010083
